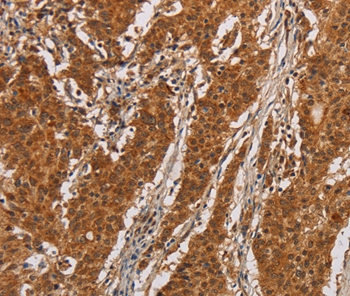

Search results: IL17RA
Product group Antibodies
Anti-IL17RA AntibodyAMAB91617
ApplicationsWestern Blot
ReactivityHuman
TargetIL17RA
- SizePrice
Product group Antibodies
Anti-IL17RA AntibodyAMAB91619
ApplicationsWestern Blot
ReactivityHuman
TargetIL17RA
- SizePrice
Product group Antibodies
Anti-IL17RA Antibody144-10052
ApplicationsWestern Blot
ReactivityHuman, Mouse, Rat
TargetIL17RA
- SizePrice
Product group Antibodies
Anti-IL17RA AntibodyA98800
ApplicationsWestern Blot, ELISA
ReactivityHuman, Mouse
- SizePrice
Product group Antibodies
Anti-IL17RA AntibodyA98801
ApplicationsWestern Blot, ELISA
ReactivityHuman, Mouse
- SizePrice
Product group Antibodies
Anti-IL17RA AntibodyA54481
ApplicationsWestern Blot, ELISA
ReactivityHuman, Mouse, Rat
- SizePrice
Product group Antibodies
Anti-IL17RA AntibodyA45570
ApplicationsImmunoHistoChemistry
ReactivityHuman
- SizePrice
Product group Antibodies
ApplicationsWestern Blot, ELISA
ReactivityHuman
TargetIL17RA
- SizePrice
Didn't find what you were looking for?
Search through our product groups to find the right product
Back to overview